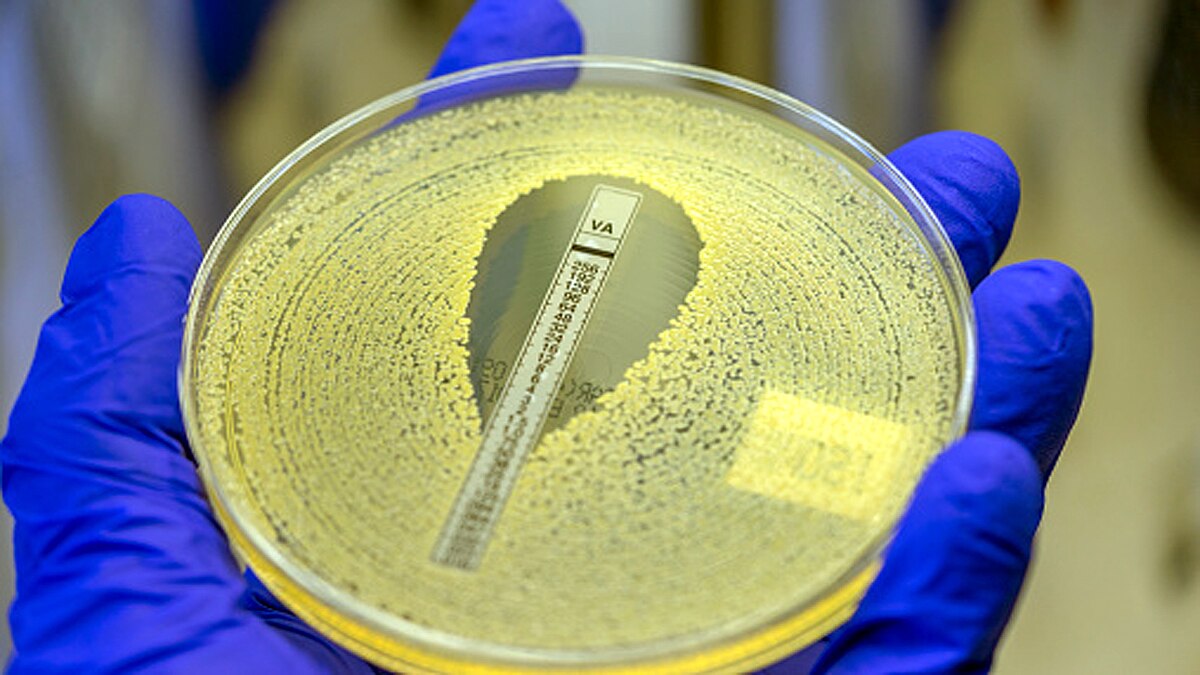
Antibiotic resistance Pandemic
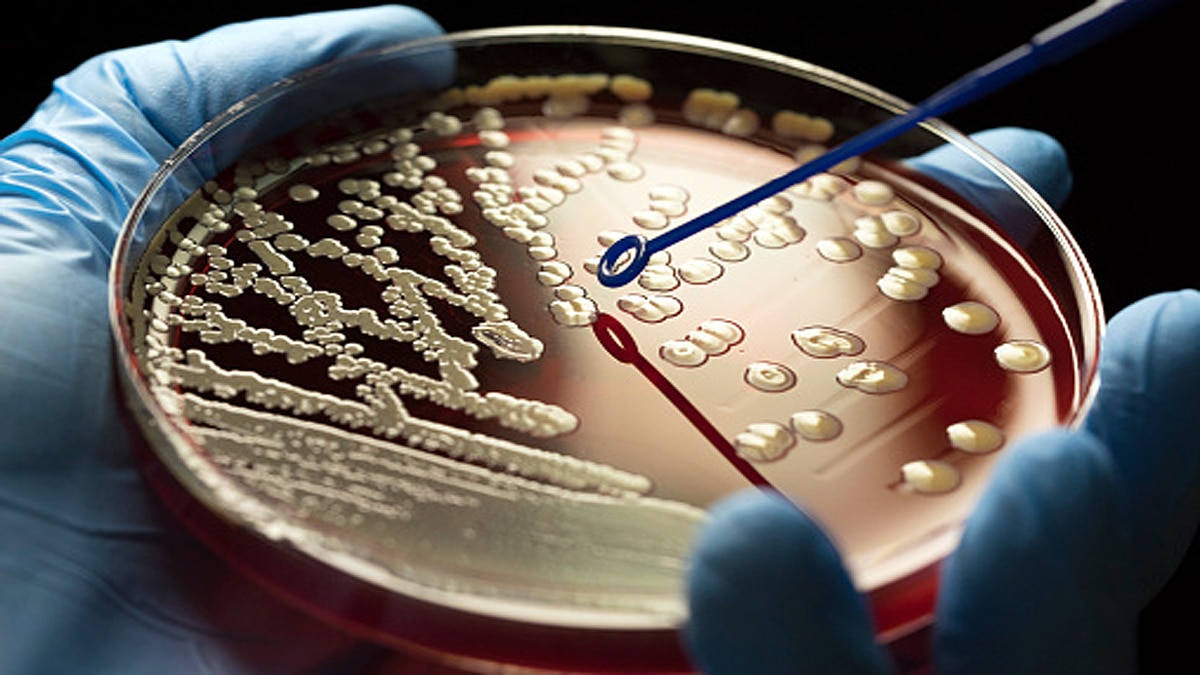
Antibiotic resistance Pandemic
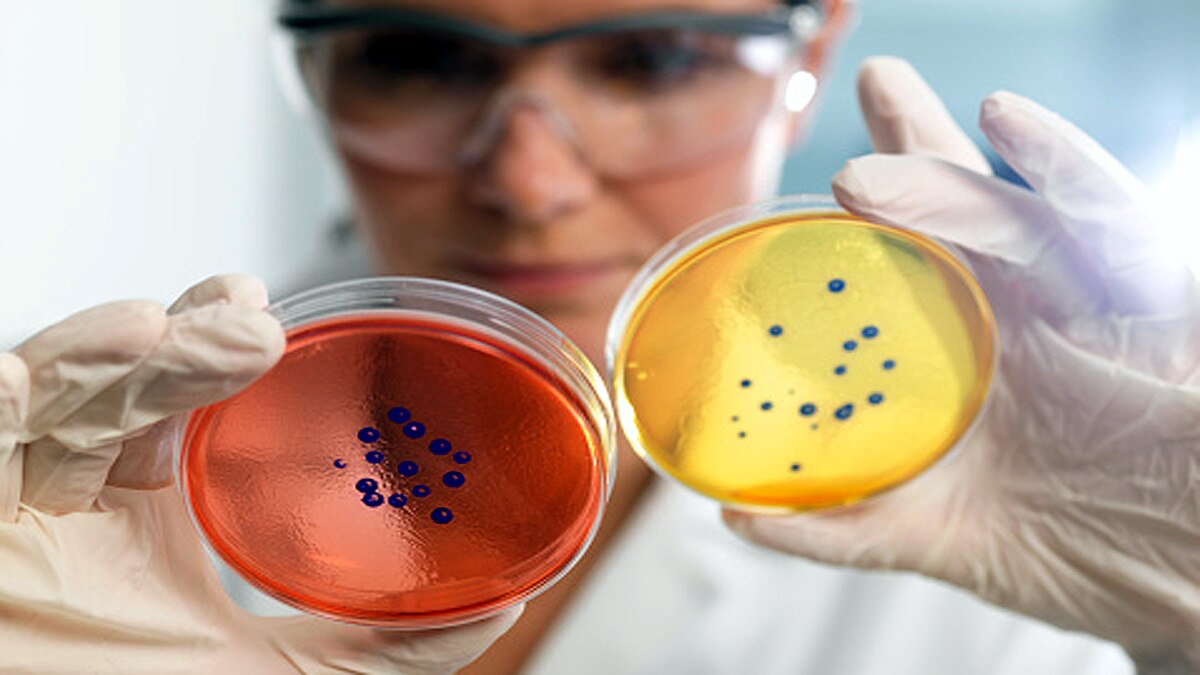
Antibiotic resistance Pandemic
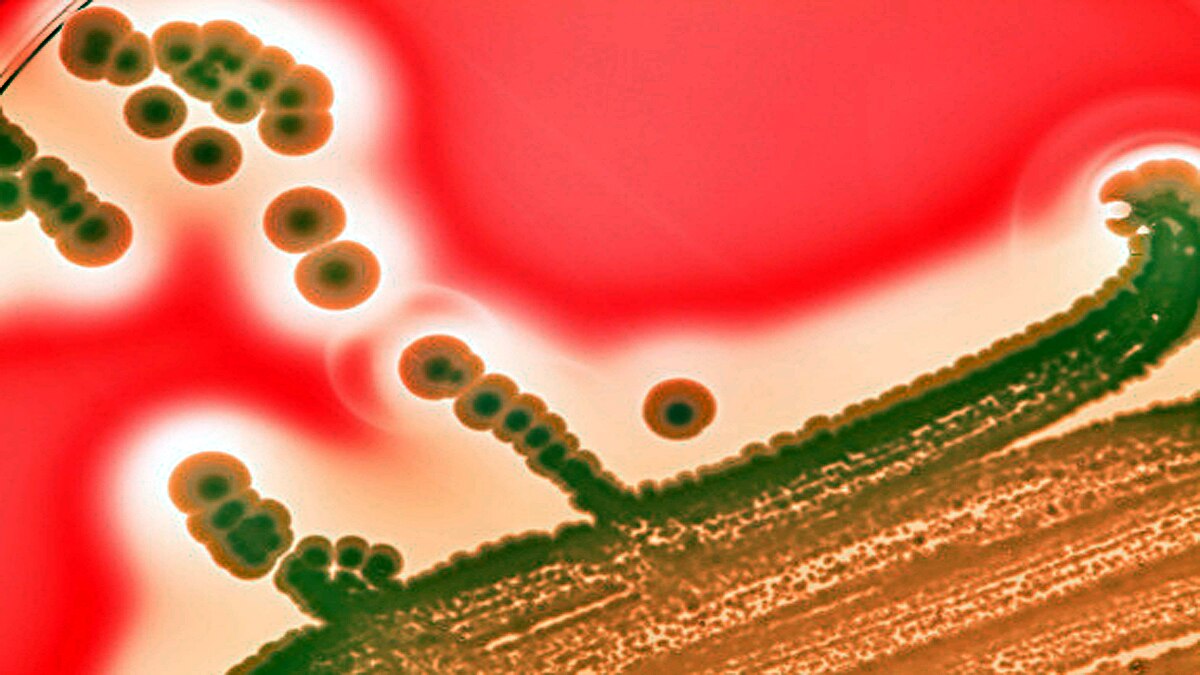
Antibiotic resistance Pandemic

अगली महामारी में नहीं काम आएंगी एंटीबायोटिक दवाएं, रिसर्च में खुलासा
एंटीबायोटिक दवाएं आधुनिक चिकित्सा पद्धतियों की सबसे बड़ी खोज हैं. ये हर साल लाखों-करोड़ों लोगों की जान बचाती हैं, लेकिन अगली महामारी ऐसी होगी, जिसपर एंटीबायोटिक, एंटीमाइक्रोबियल, एंटीबैक्टीरियल दवाओं का असर नहीं होगा. एक नई स्टडी में यह जानकारी दी गई है. यानी इंसान की जाति एक ऐसे टाइम बम के साथ जी रही है, जो कभी भी फट सकता है और उसे लेकर इंसान कुछ नहीं रहे हैं. जो कुछ हो भी रहा है वह काफी नहीं है. (फोटोःगेटी)
एंटीबायोटिक्स (Antibiotics) क्या है? ये एक तरह एंटीमाइक्रोबियल पदार्थ (Antimicrobial Substance) होता है जो बैक्टीरिया के खिलाफ संघर्ष करता है. यह किसी भी तरह के बैक्टीरियल संक्रमण को रोकने में कारगर होता है. एंटीबायोटिक दवाओं का उपयोग शरीर में सूक्ष्म जीवों के जरिए फैलने वाले संक्रमण को रोकने में किया जाता है. ताकि वो शरीर में विकसित न हो और अंत में खत्म हो जाएं. (फोटोःगेटी)
एंटीबायोटिक्स की ताकत और आसानी से मिलने की वजह से इन्हें पूरी दुनिया में माना जाता है. लेकिन ये बहुत ज्यादा उपयोग में लाई जा रही हैं. हालांकि, कुछ खतरनाक बैक्टीरिया हैं जो एंटीबायोटिक दवाओं को बेअसर कर देती हैं. या यूं कहें कि एंटीबायोटिक का इनपर कोई असर नहीं होता. यानी अगली महामारी बैक्टीरिया से संबंधित भी हो सकती है. इस समय एंटीबायोटिक रोधी बीमारियों को लेकर पूरी दुनिया के वैज्ञानिक और रिसर्चर चिंतित हैं. यह एक बड़ी समस्या बनकर सामने आ रहा है. (फोटोःगेटी)
विश्व स्वास्थ्य संगठन (WHO) ने एंटीमाइक्रोबियल रेजिसटेंस को वैश्विक खतरा बताया है. संगठन ने कहा कि यह भविष्य में विकराल रूप ले सकता है. क्योंकि ऐसी दिक्कतें अब ही शुरु हो चुकी हैं. ऐसी बीमारियों दुनिया के किसी भी देश के किसी भी कोने से फैल सकती हैं. ये किसी भी उम्र के लोगों को चपेट में ले सकती हैं. बीमारी तब और खतरनाक हो जाती है, जब उसपर दवाओं का असर नहीं होता. (फोटोःगेटी)
डच बायोटेक/लाइफ साइंस संस्था होलैंडबायो के एमडी एनीमीक वर्कामैन कहते हैं कि एंटीबायोटिक रोधी बीमारियां बड़ा खतरा हैं. ये सार्वजनिक स्वास्थ्य के लिए भारी चेतावनी हैं. क्योंकि अगली महामारी बैक्टीरिया से संबंधित हो सकती है. यह ऐसा बैक्टीरिया होगा जिसपर एंटीबायोटिक दवाओं का असर नहीं होगा. हालांकि कुछ छोटी और मध्यम दर्जे की दवा कंपनियां अपनी तरफ से प्रयास करके नई एंटीबायोटिक दवाएं बना रही हैं, लेकिन जब बड़े पैमाने पर कोई एंटीबायोटिक रोधी बीमारी फैलेगी तो उसे रोकने के लिए यह दवाएं काफी नहीं होंगी. (फोटोःगेटी)
The next 'pandemic' is antibiotic resistance, a ticking time bomb.
— World and Science (@WorldAndScience) June 20, 2021
Here is why we are doing nothing to stop it:https://t.co/er0yMAHQlS
एनीमीक वर्कामैन कहते हैं कि दुनिया भर की दवा कंपनियों और रिसर्च संस्थाओं को ऐसी बैक्टीरिया पर और माइक्रोब्स पर नजर रखनी चाहिए जो ऐसी महामारी फैला सकते हैं. उन्हें रोकने के लिए R&D पर पैसा खर्च करना चाहिए. क्योंकि पैथोजेनिक फंजाई (Pathogenic Fungi) और एंटीबायोटिक रोधी बैक्टीरिया (Antibiotic Resistance Bacteria) तेजी से फैलना शुरु हो रहे हैं. (फोटोःगेटी)
एंटीबायोटिक दवाएं बनाने वाली कंपनियों को अपनी दवाओं का फिर से रिव्यू करके उनकी ताकत को बढ़ाना होगा. या फिर अपनी दवाओं में कोई ऐसा तत्व डालना होगा जिसे एंटीबायोटिक रोधी बैक्टीरिया समझ न पाए और खत्म हो जाए. जैसे ही ऐसी कोई दवा बने, उसका तत्काल क्लीनिकल ट्रायल किया जाए और बड़े पैमाने पर उत्पादन की क्षमता तैयार रखने की कोशिश की जाए. (फोटोःगेटी)
वर्कामैन ने कहा कि दुनियभर के रईस लोगों को अपने पैसे मेडिकल रिसर्च में लगाने चाहिए. ताकि दवा कंपनियां और रिसर्च संस्थाएं नई दवाओं को खोज सकें. नीदरलैंड्स बाढ़ से अक्सर परेशान रहता था. बाढ़ की वजह से ऐसे बैक्टीरिया आते थे जो आसानी से खत्म नहीं होते थे. उनपर दवाओं का असर नहीं होता था. अंत में नीदरलैंड्स ने डेल्टा वर्क करके नदियों और सागरों में बांध बनाने शुरु किये ताकि बाढ़ को रोका जा सके. इसी तरह पूरी दुनिया को संक्रामक बीमारी डेल्टा वर्क करके प्रोजेक्ट चलाना चाहिए. ताकि संक्रामक बीमारियों की लहर और बाढ़ को रोका जा सके. (फोटोःगेटी)
बेल्जियम में कुछ शोधकर्ताओं ने नए एंटीबायोटिक बनाने को लेकर कुछ काम किया है. वो आर्टिफिशियल इंटेलिजेंस की मदद से नया फॉर्मूला निकाल रहे हैं. ताकि एंटीबायोटिक रोधी बीमारियों को रोका जा सके. लेकिन दिक्क्त ये है कि उन्हें बहुत ज्यादा आर्थिक मदद नहीं मिल पा रही है. इसलिए जरूरी है कि एंटीबायोटिक रोधी बैक्टीरिया को खत्म करने के लिए रिसर्च हों. क्योंकि इंसान की सभ्यता को बचाने के लिए जरूरी है सामूहिक प्रयास के जरिए कोई खोज की जाए. (फोटोःगेटी)